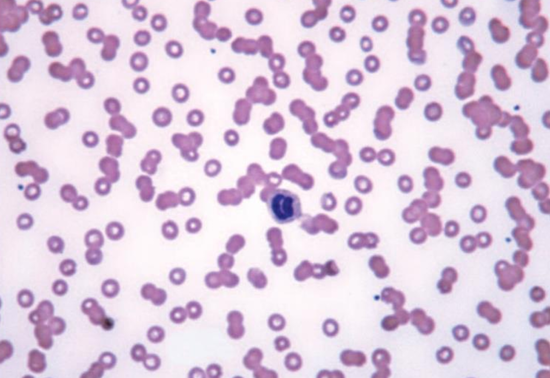
term image

1/180
Looks like no tags are added yet.
Name | Mastery | Learn | Test | Matching | Spaced | Call with Kai |
|---|
No analytics yet
Send a link to your students to track their progress
Hodgkin's lymphoma



HL morphology and IHC

HL pathogenesis

classical HL

classical HL presentation

HL staging

prognostic markers in HL

HL treatment

long term complications of early stage HL

“PET-adapted” treatment- advanced stage HL

PET adapted treatment

role of radiation (XRT) in HL

relapsed HL

hematologic malignancies expressing CD30

brentuximab vedotin- MOA

ECHELON-1: BV+AVD in advanced stage HL

challenges of treating elderly pts with HL

refractory HL: targeting PD-1

nivolumab in advanced HL

nivolumab in advanced HL conclusions

HL summary

T cell lymphomas

T cell lymphomas introduction

most common TCL subtypes

T-cell lymphoma survival

peripheral T cell lymphoma: PTCL-NOS

anaplastic large T cell lymphoma

mycosis fungoides- cutaneous T-cell lymphoma

adult T-cell leukemia/lymphoma (ATLL)

HTLV-1 and adult T-cell leukemia/lymphoma (ATLL)

angioimmunoblastic T-cell lymphoma

extranodal NK/T-cell lymphoma- nasal type

hepatosplenic T-cell lymphoma

enteropathy associated T-cell lymphoma presentation

myeloma epidemiology

multiple myeloma is a ____ cancer

spectrum of plasma cell disorders

plasma cell disorders

morphology of MM cell

MM is a blood cancer found primarily in the
-bone marrow

MM cells secrete
-monoclonal immunoglobulins

in MM, an increased number of _____ oversecrete _____
-malignant plasma cells; an abnormal antibody called an “M protein”

serum and urine protein electrophoresis (SPEP and UPEP) quantify
-monoclonal Ab secretion

SIFE

MM by immunoglobulin type

MM clinical presentation

MM diagnostic criteria

myeloma alters
-bone metabolism



spinal cord syndrome

diagnostic tests

MM prognosis- karyotype and FISH

prognosis of myeloma

natural history of myeloma

myeloma treatments

myeloma chemo principles

treatment paradigm

MM treatments by class

commonly used MM regimens

SWOG S0777 trial

bone marrow transplant

bispecific antibodies in relapsed/refractory plasma cell disorders

myeloma complications- infections

myeloma complications- thrombosis

myeloma complications- bone


MGUS v. SMM v. MM

MGUS and SMM- progression to MM

Waldenstrom macroglobulinemia

AL amyloidosis

light chain amyloid deposition in target organs

key points

cellular therapy, HCT/HSCT/SCT/BMT, adoptive cell therapy definitions

normal hematopoiesis

types of HCT


auto- v. allo-HCT

auto HCT steps

allo HCT steps

auto HCT common indications- malignant, non-malignant

allo HCT common indications

indications for HCT

pre-HCT assessment

mobilization strategies

donor selection- HLA matching

a “clinical match”

likelihood of finding 8/8 HLA match donor

donor selection algorithm for allogeneic HCT

conditioning/preparative regimens


complications post-HCT


complications post-HCT

risk factors, infectious, non-infectious

supportive care- anti-microbial prophylaxis

supportive care

immunizations

allogeneic HCT- specific complications

GvHD and GvT responses

GvHD

pathogenesis of GvHD

GvHD syndromes after alloHCT
